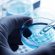

Ospedale Carlo Urbani, al via i lavori
di ampliamento del pronto soccorso

Rendering del progetto
Lavori in corso all’Ospedale “Carlo Urbani”: oggi è partito infatti il cantiere al Pronto Soccorso di Jesi sulla base della consegna dei lavori avvenuta ieri, mercoledì, relativamente all’intervento di ampliamento del PS e di adeguamento dei percorsi interni, presenti il responsabile dei lavori, l’ingegner Francesco Rossetti, e la ditta esecutrice.
L’intervento prevede un ampliamento esterno, sulla facciata a sinistra della camera calda, che ospiterà studi medici e relativo servizio igienico a disposizione del personale. Questo volume sarà collegato al corridoio di Radiologia tramite l’apertura di un varco nella facciata esistente e consentirà di liberare spazi all’interno dell’attuale Pronto Soccorso ed avere così maggiore fruibilità da parte dell’utenza.
Nello specifico, al Pronto Soccorso, sono previsti interventi finalizzati all’ingrandimento della sala di attesa principale in modo tale da poter ottenere maggior spazio per il distanziamento e l’accesso di pazienti non barellati. Sempre nell’ambito della riorganizzazione dell’accoglienza, a seguito dei lavori, si libereranno alcune stanze interne al pronto soccorso che saranno riqualificate ed adibite alla valutazione immediata dell’utente in ingresso ed eventualmente isolarlo prima di accedere alla zona interna.
Un altro intervento all’interno prevede di modificare l’assetto delle sale di “attesa barellati” post triage e gli studi medici adiacenti in maniera tale da aumentare l’area dedicata all’attesa barellati e dunque isolare eventuali pazienti che dovessere essere infetti.
L’investimento per l’esecuzione dei lavori ammonta a circa 658.000 euro ed è finanziato per circa 319.000 euro con i fondi Pnnr, mentre la restante parte con le risorse economiche aggiuntive messe a disposizione dalla Regione.
Torna alla home page